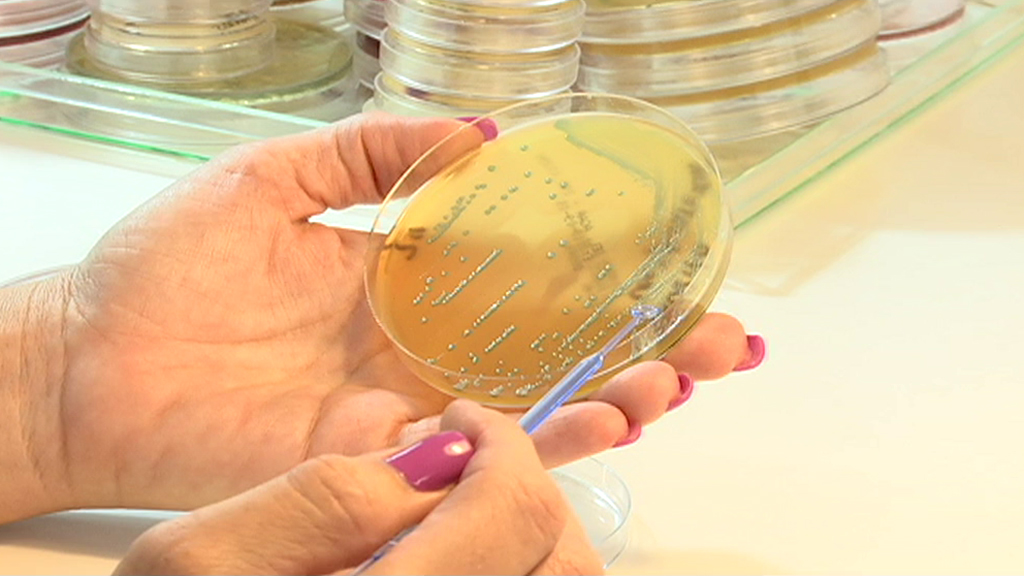

Bajan a 34 los hospitalizados por listerioris, de los 214 casos confirmados
31 están ingresados en hospitales públicos y los tres restantes en centros privados, mientras que en la UCI continúan en tratamiento tres estos enfermos
Tres nuevos casos de infección confirmada por Listeria, de los que dos son embarazadas, una de las cuales ha dado a luz y el recién nacido está en tratamiento
La cifra de hospitalizados por infección confirmada o con sospecha por Listeria en Andalucía ha bajado a 34, tres menos que este martes, de los que 15 son embarazadas, una menos que el martes, y los casos confirmados han aumentado en tres, hasta los 214 enfermos.
La Consejería andaluza de Salud ha destacado este miércoles que en las últimas veinticuatro horas no ha habido nuevos abortos, ni recién nacidos con infección, ni fallecimientos, por lo que el balance de este brote de listeriosis se mantiene en tres fallecidos y siete abortos.
De los 34 hospitalizados, 31 están ingresados en hospitales públicos y los tres restantes en centros privados, mientras que en la UCI continúan en tratamiento tres estos enfermos, una cifra igual que la de ayer.
La mayoría de los hospitalizados en centros públicos: 22 enfermos, están ingresados en hospitales de Sevilla, siete menos que ayer; otros cinco en Cádiz; dos en Málaga; uno en Huelva y otro en Granada.
Este martes se notificaron tres nuevos casos de infección confirmada por Listeria monocytogenes, de los que dos son embarazadas, una de las cuales ha dado a luz y el recién nacido está en tratamiento y pendiente de los resultados de los cultivos, mientras que una segunda mujer continua su embarazo y está en tratamiento.
Salud ha señalado que la reducción del número de nuevos casos diarios "se mantiene de forma sostenida" desde el 23 de agosto.
La distribución provincial de los casos confirmados señala que el brote de listeriosis se concentra en la provincia de Sevilla, con 175 casos lo que supone el 82 % del total, seguido de Huelva (17), Cádiz (11), Málaga (6) y Granada (5).
La ampliación del tratamiento a embarazadas asintomáticas que hubieran comido el alimento contaminado se mantiene "a buen ritmo gracias al trabajo extraordinario que están haciendo todos los médicos de familia, los ginecólogos y las matronas, así como al comportamiento sereno y ejemplar de las mujeres embarazadas", según el comunicado.
Con datos provisionales hasta el martes a las 12:00 horas, se ha contactado ya con 21.533 gestantes y se ha recomendado un tratamiento con amoxicilina oral a 1.275 mujeres.
El portavoz del gabinete técnico de la Consejería de Salud y Familias para el seguimiento de la listeriosis, José Miguel Cisneros, ha opinado que los datos "continúan mostrando que el brote está en remisión por la reducción sostenida del número de casos nuevos de infección y de pacientes hospitalizados".









